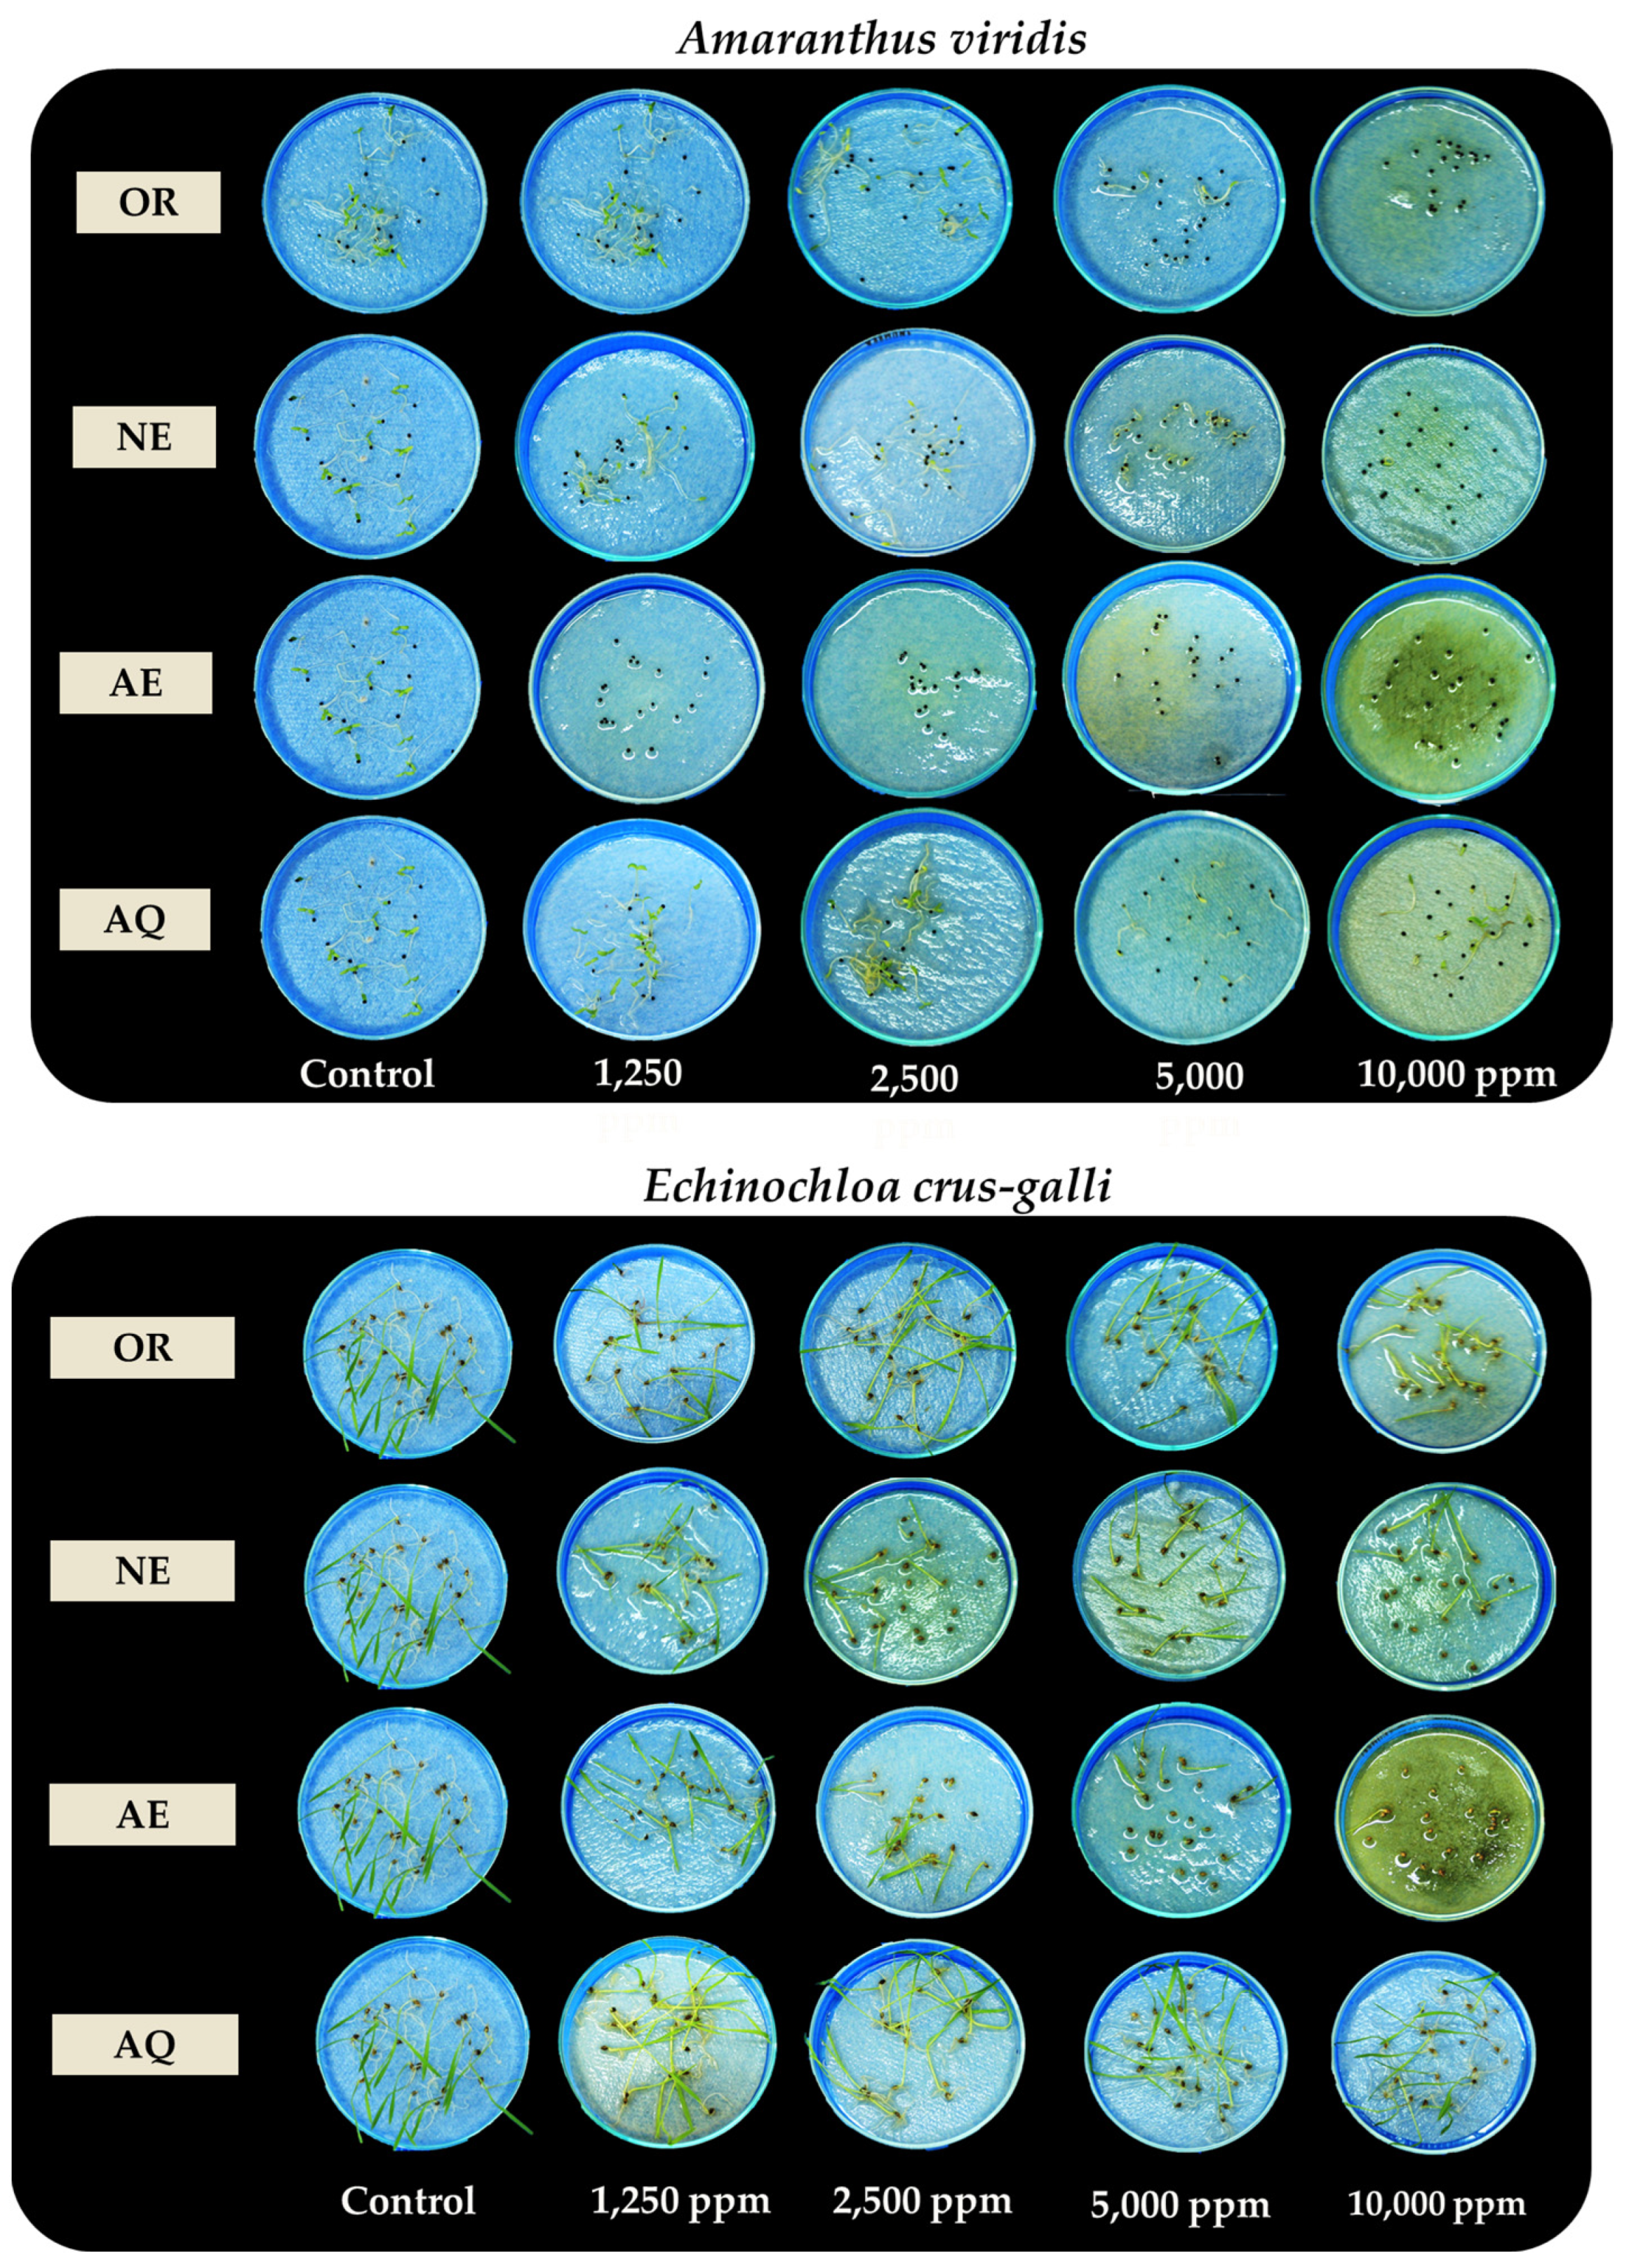
Plants 13 02085 g003

Allelopathic Effects of Sugarcane Leaves: Optimal Extraction Solvent, Partial Separation of Allelopathic Active Fractions, and Herbicidal Activities
Abstract
1. Introduction
2. Results
2.1. Allelopathic Effects of Solvent Extracts against Weeds and the Crude Extract Yields
2.2. Allelopathic Effects of the Fractions Extracted by Solvent Partitioning
2.3. GC-MS Analysis of the Acidic Fractions Separated from Sugarcane Leaf Extracts
2.4. Investigation of AE Formulation Herbicidal Activity in Pot Experiments
2.5. AE Formulation Induced Oxidative Damage
3. Discussion
4. Materials and Methods
- Site description
- Plant material
- Test plant species
4.1. Allelopathic Effects of Solvent Extracts against Weeds and the Crude Extract Yields
4.2. Solvent Partitioning of the Active Fractions and Bioassay
4.3. GC-MS Separation of Compounds in the Active Fractions of Sugarcane Leaf Extracts
4.4. Herbicidal Activities of the Active Fractions
4.5. Estimating Membrane Injury
4.6. Lipid Peroxidation
- A532 = the absorbance at 532 nm, A600 = the absorbance at 600 nm;
- Vf = final volume;
- Ve = volume of TCA used for extraction;
- Va = volume of supernatants used in absorbance detection;
- FW = fresh weight of samples.
4.7. Hydrogen Peroxide (H2O2) Content
- A390 = the absorbance at 390 nm;
- Vf = final volume;
- Ve = volume of TCA used for extraction;
- Va = volume of supernatants used in absorbance detection;
- FW = fresh weight of samples.
- Statistical Analysis
5. Conclusions
Author Contributions
Funding
Data Availability Statement
Conflicts of Interest
References
- Laosinwattana, C.; Wichittrakarn, P.; Teerarak, M. Chemical composition and herbicidal action of essential oil from Tagetes erecta L. leaves. Ind. Crop. Prod. 2018, 126, 129–134. [Google Scholar] [CrossRef]
- Kostina-Bednarz, M.; Płonka, J.; Barchanska, H. Allelopathy as a source of bioherbicides: Challenges and prospects for sustainable agriculture. Rev. Environ. Sci. 2023, 22, 471–504. [Google Scholar] [CrossRef]
- Dayan, F.E.; Owens, D.K.; Duke, S.O. Rationale for a natural products approach to herbicide discovery. Pest Manag. Sci. 2012, 68, 519–528. [Google Scholar] [CrossRef] [PubMed]
- Lun, T.L.; Iwasaki, A.; Suenaga, K.; Kato-Noguchi, H. Two allelopathic substances from Plumbago rosea stem extracts and their allelopathic effects. Agronomy 2020, 12, 2020. [Google Scholar] [CrossRef]
- Chon, S.U.; Jang, H.G.; Kim, D.K.; Kim, Y.M.; Boo, H.O.; Kim, Y.J. Allelopathic potential in lettuce (Lactuca sativa L.) plants. Sci. Hortic. 2005, 106, 309–317. [Google Scholar] [CrossRef]
- Duke, S.O.; Rimando, A.M.; Schrader, K.K.; Cantrell, C.; Meepagala, K.M.; Wedge, D.E.; Tabanca, N.; Dayan, F.E. Natural Products for Pest Management. In Selected Topics in the Chemistry of Natural Products; Ikan, R., Ed.; World Scientific Publishing Company: Singapore, 2007; pp. 209–251. [Google Scholar]
- Einhellig, F.A. Allelopathy: Organisms, Processes, and Applications; ACS Symposium Series: Washington, DC, USA, 2006; pp. 260–269. [Google Scholar]
- Spigno, G.; Tramelli, L.; Faveri, D.M.D. Effects of extraction time, temperature and solvent on concentration and antioxidant activity of graph marc phenolics. J. Food Eng. 2007, 81, 200–208. [Google Scholar] [CrossRef]
- Chotsaeng, N.; Laosinwattana, C.; Charoenying, P. Herbicidal activities of some allelochemicals and their synergistic behaviors toward Amaranthus tricolor L. Molecules 2007, 22, 1841. [Google Scholar] [CrossRef] [PubMed]
- Heisey, R.M.; Heisey, T.K. Herbicidal effects under field conditions of Ailanthus altissima bark extract, which contains ailan-thone. Plant Soil 2003, 256, 85–99. [Google Scholar] [CrossRef]
- Duke, S.O. Interaction of chemical pesticides and their formulation ingredients with microbes associated with plants and plant pests. J. Agric. Food Chem. 2018, 66, 7553–7561. [Google Scholar] [CrossRef]
- Wichittrakarn, P.; Teerarak, M.; Charoenying, P.; Laosinwattana, C. Effects of natural herbicide from Tagetes erecta on Echinochloa crus-galli (L.) Beauv. Allelopath. J. 2018, 43, 17–30. [Google Scholar] [CrossRef]
- Poonpaiboonpipat, T.; Krumsri, R.; Kato-Noguchi, H. Allelopathic and Herbicidal Effects of Crude Extract from Chromolaena odorata (L.) R.M.King and H.Rob. on Echinochloa crus-galli and Amaranthus viridis. Plants 2021, 10, 1609. [Google Scholar] [CrossRef] [PubMed]
- Abbasi, H.; Rezaei, K.; Rashidi, L. Extraction of essential oils from the seeds of pomegranate using organic solvents and supercritical CO2. JAOCS J. Am. Oil Chem. Soc. 2008, 85, 83–89. [Google Scholar] [CrossRef]
- Do, Q.D.; Angkawijaya, A.E.; Tran-Nguyen, P.L.; Huynh, L.H.; Soetaredjo, F.E.; Ismadji, S.; Ju, Y.H. Effect of extraction solvent on total phenol content, total flavonoid content, and antioxidant activity of Limnophila aromatica. J. Food Drug Anal. 2014, 22, 296–302. [Google Scholar] [CrossRef] [PubMed]
- Chatha, S.A.S.; Anwar, F.; Manzoor, M. Evaluation of the antioxidant activity of rice bran extracts using different antioxidant assays. Grasasy Aceites 2006, 57, 328–335. [Google Scholar]
- Siddhuraju, P.; Becker, K. Antioxidant properties of various solvent extracts of total phenolic constituents from three different agroclimatic origins of drumstick tree (Moringa oleifera Lam.) leaves. J. Agric. Food Chem. 2003, 51, 2144–2155. [Google Scholar] [CrossRef]
- Thinh, N.H.; Laosinwattana, C.; Wichittrakarn, P. Optimal extraction solvents use for extraction of Thunbergia laurifolia Linn. leaves and its mode of action on weed control. Int. J. Agric. Technol. 2018, 14, 2067–2076. [Google Scholar]
- Raza, Q.U.A.; Bashir, M.A.; Rehim, A.; Sial, M.U.; Ali Raza, H.M.; Atif, H.M.; Geng, Y. Sugarcane industrial byproducts as challenges to environmental safety and their remedies: A review. Water 2021, 13, 3495. [Google Scholar] [CrossRef]
- Sindhu, R.; Gnansounou, E.; Binod, P.; Pandey, A. Bioconversion of sugarcane crop residue for value added products–An overview. Renew. Energy 2016, 98, 203–215. [Google Scholar] [CrossRef]
- Chauhan, M.K.; Chaudhary, S.; Kumar, S. Life cycle assessment of sugar industry: A review. Renew. Sust. Energy Rev. 2011, 15, 3445–3453. [Google Scholar] [CrossRef]
- Yang, S.; He, H.; Lu, S.; Chen, D.; Zhu, J. Quantification of crop residue burning in the field and its influence on ambient air quality in Suqian, China. Atmos. Environ. 2008, 42, 1961–1969. [Google Scholar] [CrossRef]
- Kumar, I.; Bandaru, V.; Yampracha, S.; Sun, L.; Fungtammasan, B. Limiting rice and sugarcane residue burning in Thailand: Current status, challenges and strategies. J. Environ. Manag. 2020, 276, 111228. [Google Scholar] [CrossRef]
- Viator, R.P.; Johnson, R.M.; Grimm, C.C.; Richard, E.P., Jr. Allelopathic, autotoxic, and hormetic effects of postharvest sugarcane residue. J. Agron. 2006, 98, 1526–1531. [Google Scholar] [CrossRef]
- Sampietro, D.A.; Vattuone, M.A.; Isla, M.I. Plant growth inhibitors isolated from sugarcane (Saccharum officinarum) straw. Plant Physiol. 2006, 163, 837–846. [Google Scholar] [CrossRef] [PubMed]
- Terrero Matos, W.; Castellanos, L. Allelopathic effect of sugar cane straw (Saccharum spp. hybrid) on the arvensis Achyranthes aspera, var. Indica L., under controlled conditions. INGE CUC 2022, 18, 169–176. [Google Scholar]
- Majeed, A.; Muhammad, Z.; Hussain, M.; Ahmad, H. In vitro allelopathic effect of aqueous extracts of sugarcane on germination parameters of wheat. Acta Agric. Slov. 2017, 109, 349–356. [Google Scholar] [CrossRef]
- Singh, P.; Suman, A.; Shrivastava, K. Isolation and identification of allelochemicals from sugarcane leaves. Allelopath. J. 2003, 12, 71–80. [Google Scholar]
- Xavier, T.F.; Arun, V.R. Sensitivity pattern of bacterial pathogens on the medicinal weed L. camara L. J. Plant Sci. 2007, 2, 579–582. [Google Scholar]
- Mugao, L.G.; Muturi, P.W.; Gichimu, B.M.; Njoroge, E.K. In vitro control of Phytophthora infestans and Alternaria solani using crude extracts and essential oils from selected plants. Int. J. Agron. 2020, 2020, 1–10. [Google Scholar] [CrossRef]
- Wongkaew, P.; Sinsiri, W. Effectiveness of ringworm cassia and turmeric plant extracts on growth inhibition against some important plant pathogenic fungi. Am. J. Plant Sci. 2014, 5, 615–626. [Google Scholar] [CrossRef]
- Masoko, P.; Picard, J.; Eloff, J.N. Antifungal activities of six south African Terminalia species (Combretaceae). J. Ethnopharmacol. 2005, 99, 301–308. [Google Scholar] [CrossRef]
- Fuentes-Gandara, F.; Torres, A.; Fernández-Ponce, M.T.; Casas, L.; Mantell, C.; Varela, R.; Macias, F.A. Selective fractionation and isolation of allelopathic compounds from Helianthus annuus L. leaves by means of high-pressure techniques. J. Supercrit. Fluids 2019, 143, 32–41. [Google Scholar] [CrossRef]
- Li, J.; Chen, L.; Chen, Q.; Miao, Y.; Peng, Z.; Huang, B.; Du, H. Allelopathic effect of Artemisia argyi on the germination and growth of various weeds. Sci. Rep. 2021, 11, 4303. [Google Scholar] [CrossRef]
- Zhang, Y.J.; Lu, S.B.; Gao, H.D. Allelopathic effect of different solvent extraction from seed of Taxus chinensis var. Mairei on cabbage seed germination and seedling growth. Chin. Agric. Sci. Bull. 2010, 26, 190–194. [Google Scholar]
- Wang, S.; Yin, B.; Wang, Y.; Chen, S.; Qian, H. Study on comparison of different methods on extracting total triterpenoids from Sanguisorba officinalis and its antioxidant activities. Food Res. Dev. 2019, 40, 111–115. [Google Scholar]
- Sasidharan, S.; Chen, Y.; Saravanan, D.; Sundram, K.M.; Latha, L.Y. Extraction, isolation and characterization of bioactive compounds from plants’ extracts. Afr. J. Tradit. Complement. Altern. Med. 2011, 8, 1–10. [Google Scholar] [CrossRef]
- Vaou, N.; Stavropoulou, E.; Voidarou, C.; Tsakris, Z.; Rozos, G.; Tsigalou, C.; Bezirtzoglou, E. Interactions between medical plant-derived bioactive compounds: Focus on antimicrobial combination effects. Antibiotics 2022, 11, 1014. [Google Scholar] [CrossRef] [PubMed]
- Teerarak, M.; Laosinwattana, C.; Charoenying, P. Evaluation of allelopathic, decomposition and cytogenetic activities of Jasminum officinale L. f. var. grandiflorum (L.) Kob. on bioassay plants. Bioresour. Technol. 2010, 101, 5677–5684. [Google Scholar] [CrossRef]
- Moreno-Robles, A.; Cala Peralta, A.; Zorrilla, J.G.; Soriano, G.; Masi, M.; Vilariño-Rodríguez, S.; Fernández-Aparicio, M. Identification of structural features of hydrocinnamic acid related to its allelopathic activity against the parasitic weed Cuscuta campestris. Plants 2022, 11, 2846. [Google Scholar] [CrossRef] [PubMed]
- Wu, H.B.; Ma, L.H.; Li, X.M.; Liu, T.T. Selective phytotoxic effects of sesquiterpenoids from Sonchus arvensis as a preliminary approach for the biocontrol of two problematic weeds of wheat. J. Agric. Food Chem. 2022, 70, 9412–9420. [Google Scholar] [CrossRef]
- Govindappa, M.; Prathap, S.; Vinay, V.; Channabasava, R. Chemical composition of methanol extract of endophytic fungi, Alternaria sp. of Tebebuia argentea and their antimicrobial and antioxidant activity. Int. J. Biol. Pharm. Res. 2014, 5, 861–869. [Google Scholar]
- Papitha, R.; Lokesh, R.; Kaviyarasi, R.; Selvaraj, C.I. Phytochemical screening, FT-IR and gas chromatography mass spectrometry analysis of Tinospora cordifolia (Thunb.) Miers. Int. J. Pharmacogn. Phytochem. Res. 2016, 8, 2020–2024. [Google Scholar]
- Elqahtani, M.M.; El-Zohri, M.; Galal, H.K.; El-Enany, A.E. GC-MS analysis of crude extracts from Heliotropium bacciferum L. and their allelopathic effects on Zea mays L. and Vicia faba L. Allelopath. J. 2017, 41, 51–64. [Google Scholar] [CrossRef]
- Guo, H.; Stüben, D.; Berner, Z.; Yu, Q. Characteristics of arsenic adsorption from aqueous solution: Effect of arsenic species and natural adsorbents. J. Appl. Geochem. 2009, 24, 657–663. [Google Scholar] [CrossRef]
- Gilman, H.; Miles, D.H. The Preparation of Cyclohexyltriphenylsilane. J. Am. Chem. Soc. 1958, 80, 611–613. [Google Scholar] [CrossRef]
- Kalaivani, K.; Senthil-Nathan, S.; Stanley-Raja, V.; Vasantha-Srinivasan, P. Physiological and biochemical alterations in Vigna radiata L. triggered by sesame derived elicitors as defense mechanism against Rhizoctonia and Macrophomina infestation. Sci. Rep. 2023, 13, 13884. [Google Scholar] [CrossRef] [PubMed]
- Lennox, A.J.; Lloyd-Jones, G.C. Selection of boron reagents for Suzuki–Miyaura coupling. Chem. Soc. Rev. 2014, 43, 412–443. [Google Scholar] [CrossRef] [PubMed]
- Einhellig, F.A. Mode of allelochemical action of phenolic compounds. In Allelopathy: Chemistry and Mode of Action of Allelochemicals; Macias, F.A., Galindo, J.C.G., Molinillo, J.M.G., Cutler, H.G., Eds.; CRC Press: Boca Raton, FL, USA, 2004; pp. 217–238. [Google Scholar]
- Li, Z.H.; Wang, Q.; Ruan, X.; Pan, C.D.; Jiang, D.A. Phenolics and plant allelopathy. Molecules 2010, 15, 8933–8952. [Google Scholar] [CrossRef] [PubMed]
- Jia, C.; Kudsk, P.; Mathiassen, S.K. Joint action of benzoxazinone derivatives and phenolic acids. J. Agric. Food Chem. 2006, 54, 1049–1057. [Google Scholar] [CrossRef]
- Bashar, H.K.; Juraimi, A.S.; Ahmad-Hamdani, M.S.; Uddin, M.K.; Asib, N.; Anwar, M.P.; Hossain, A. Documentation of phytotoxic compounds existing in Parthenium hysterophorus L. leaf and their phytotoxicity on Eleusine indica (L.) Gaertn. and Digitaria sanguinalis (L.) Scop. Toxins 2022, 14, 561. [Google Scholar] [CrossRef]
- Scognamiglio, M.; D’Abrosca, B.; Esposito, A.; Pacifico, S.; Monaco, P.; Fiorentino, A. Plant growth inhibitors: Allelopathic role or phytotoxic effects? Focus on Mediterranean biomes. Phytochem. Rev. 2013, 12, 803–830. [Google Scholar] [CrossRef]
- Marnett, L.J. Lipid peroxidation—DNA damage by malondialdehyde. Mutat. Res. Fundam. Mol. Mech. Mutagen. 1999, 424, 83–95. [Google Scholar] [CrossRef] [PubMed]
- Scrivanti, L.R.; Zunino, M.P.; Zygadlo, J.A. Tagetes minuta and Schinus areira essential oils as allelopathic agents. Biochem. Syst. Ecol. 2003, 31, 563–572. [Google Scholar] [CrossRef]
- Foyer, C.H.; Lopez-Delgado, H.; Dat, J.F.; Scott, I.M. Hydrogen peroxide- and glutathione-associated mecha-nisms of acclimatory stress tolerance and signalling. Physiol. Plant 1997, 100, 241–254. [Google Scholar] [CrossRef]
- Bajji, M.; Kinet, J.M.; Lutts, S. The use of the electrolyte leakage method for assessing cell membrane stability as a water stress tolerance test in durum wheat. Plant Growth Regul. 2002, 36, 61–70. [Google Scholar] [CrossRef]
- Mehrabi, S.S.; Sabokdast, M.; Bihamta, M.R.; Soorni, J.; Mirmazloum, I. Strigolactone-mediated amelioration of salinity stress in bread wheat: Insights from phytochemical and ion channels related genes expression analyses. Plant Stress 2023, 11, 100324. [Google Scholar] [CrossRef]
- Heath, R.L.; Packer, L. Photoperoxidation in isolated chloroplasts: I. Kinetics and stoichiometry of fatty acid peroxidation. Arch. Biochem. Biophys. 1968, 125, 189–198. [Google Scholar] [CrossRef] [PubMed]
- Singh, H.P.; Batish, D.R.; Kohli, R.K.; Arora, K. Arsenic-induced root growth inhibition in mung bean (Phaseolus aureus Roxb.) is due to oxidative stress resulting from enhanced lipid peroxidation. Plant Growth Regul. 2007, 53, 65–73. [Google Scholar] [CrossRef]
- Bahmani, R.; Razavi, F.; Mortazavi, S.N.; Gohari, G.; Juárez-Maldonado, A. Evaluation of proline-coated chitosan nanoparticles on decay control and quality preservation of strawberry fruit (cv. Camarosa) during cold storage. Horticulturae 2022, 8, 648. [Google Scholar] [CrossRef]
- Taratima, W.; Chuanchumkan, C.; Maneerattanarungroj, P.; Trunjaruen, A.; Theerakulpisut, P.; Dongsansuk, A. Effect of heat stress on some physiological and anatomical characteristics of rice (Oryza sativa L.) cv. KDML105 callus and seedling. Biology 2022, 11, 1587. [Google Scholar] [CrossRef]
- Velikova, V.; Yordanov, I.; Edreva, A.J.P.S. Oxidative stress and some antioxidant systems in acid rain-treated bean plants: Protective role of exogenous polyamines. Plant Sci. 2000, 151, 59–66. [Google Scholar] [CrossRef]

| Solvent System (Water:Ethanol [v/v]) | Crude Yield (%) | IC50 Values for Amaranthus viridis Seedling Growth (ppm) | ||
|---|---|---|---|---|
| Seed Germination | Shoot Length | Root Length | ||
| 100:00 | 1.35 | 4997 b | 6298 a | 5027 a |
| 75:25 | 4.87 | 3850 a | 6169 a | 3864 a |
| 50:50 | 8.98 | 4016 b | 4819 b | 3094 a |
| 25:75 | 12.92 | 3434 c | 4484 b | 2990 c |
| 00:100 | 10.74 | 3160 c | 3715 c | 1565 d |
| Identified Compound | Formula | Peak Area (%) | Retention Time (min) | |
|---|---|---|---|---|
| 1. | Iron, tricarbonyl l [N-(phenyl-2-pyridinylmethylene) benzenamine-N, N-] | C21H14FeN2O3 | 24.5 | 6.559 |
| 2. | 3,5-Dimethyl-1,2,4,3,5-trioxadiborolane, | C2H6B2O3 | 16.19 | 6.702 |
| 3. | Propane, 1-[1 [difluoro [(trifluoroethenyl) oxy]methyl]-1,2,2,2-tetrafluoroethoxy]-1,1,2,2,3,3,3-heptafluoro | C8F16O2 | 1.01 | 6.787 |
| 4. | Cyclohexyl methyl S-2-(dimethylamino) ethyl propyl phosphonothiolate | C14H3NO2PS | 3.08 | 6.890 |
| 5. | Pyridine, 2-chloro-3-fluoro-, 1-oxide | C5H3ClFNO | 0.57 | 7.106 |
| 6. | Cyclohexyl methyl silane | C7H16Si | 0.64 | 7.987 |
| 7. | 3-Methyl pyrazolobis (diethylboryl) hydroxide | C12H26B2N2O | 0.78 | 9.127 |
| 8. | 2,6-Bis(thiocyanatomethyl)-4-methylanisole | C12H12N2OS2 | 0.33 | 9.575 |
| 9. | Borinic acid, diethyl-, (2-ethyl-1,3,2-dioxaborolan-4-yl) methyl ester | C9H20B2O3 | 0.48 | 10.812 |
| 10. | O, O-Dimethyl [1-(4-methyl-1,2,5-oxadiazol-3-ylamino)-1-(2-fluorophenyl) methyl] phosphonate | C12H15FN3O4P | 0.46 | 11.308 |
| 11. | Bis (2-ethylhexyl) hydrogen phosphite | C16H35O3P | 2.23 | 13.401 |
| 12. | Phenol, 2, 4-bis (1,1-dimethylethyl)- | C14H22O | 10.48 | 13.585 |
| 13. | 3-(Methylthio) phenyl isothiocyanate | C8H7NS2 | 2.48 | 14.635 |
| 14. | 2H-Pyran-2-one, 6-[4,4-bis(methylthio)-1,2,3-butatrienyl]- | C11H10O2S2 | 0.75 | 15.612 |
| 15. | Dibenzylamine | C14H15N | 22.96 | 15.733 |
| 16. | Benzothiazole, 2-(2-hydroxyethylthio) | C9H9NOS2 | 10.09 | 17.626 |
| 17. | 1H-1,2,3,4-Tetrazole, 1-(4-methoxyphenyl)-5-[(phenylmethyl)sulfonyl]- | C15H14N4O3S | 0.74 | 18.081 |
| 18. | Arsenous acid, tris (trimethylsilyl) ester | C9H27AsO3Si3 | 0.62 | 18.344 |
| 19. | Caprolactone oxime, (NB)-O [(diethylboryloxy)(ethyl)boryl]- | C12H25B2NO2 | 0.32 | 20.271 |
| 20. | Tris (tert-butyldimethylsilyloxy) arsane | C18H45AsO3Si3 | 0.63 | 21.244 |
Disclaimer/Publisher’s Note: The statements, opinions and data contained in all publications are solely those of the individual author(s) and contributor(s) and not of MDPI and/or the editor(s). MDPI and/or the editor(s) disclaim responsibility for any injury to people or property resulting from any ideas, methods, instructions or products referred to in the content. |
© 2024 by the authors. Licensee MDPI, Basel, Switzerland. This article is an open access article distributed under the terms and conditions of the Creative Commons Attribution (CC BY) license (https://creativecommons.org/licenses/by/4.0/).
Share and Cite
Krumsri, R.; Kato-Noguchi, H.; Poonpaiboonpipat, T. Allelopathic Effects of Sugarcane Leaves: Optimal Extraction Solvent, Partial Separation of Allelopathic Active Fractions, and Herbicidal Activities. Plants 2024, 13, 2085. https://doi.org/10.3390/plants13152085
Krumsri R, Kato-Noguchi H, Poonpaiboonpipat T. Allelopathic Effects of Sugarcane Leaves: Optimal Extraction Solvent, Partial Separation of Allelopathic Active Fractions, and Herbicidal Activities. Plants. 2024; 13(15):2085. https://doi.org/10.3390/plants13152085
Chicago/Turabian StyleKrumsri, Ramida, Hisashi Kato-Noguchi, and Thanatsan Poonpaiboonpipat. 2024. "Allelopathic Effects of Sugarcane Leaves: Optimal Extraction Solvent, Partial Separation of Allelopathic Active Fractions, and Herbicidal Activities" Plants 13, no. 15: 2085. https://doi.org/10.3390/plants13152085
APA StyleKrumsri, R., Kato-Noguchi, H., & Poonpaiboonpipat, T. (2024). Allelopathic Effects of Sugarcane Leaves: Optimal Extraction Solvent, Partial Separation of Allelopathic Active Fractions, and Herbicidal Activities. Plants, 13(15), 2085. https://doi.org/10.3390/plants13152085

